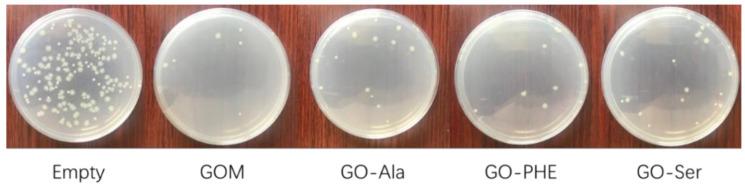
https://cdn.ncbi.nlm.nih.gov/pmc/blobs/bace/7589175/ac570bf4bb78/membranes-10-00296-g009.jpg

用于金属离子渗透、插入及抗菌性能的氨基酸交联氧化石墨烯膜
Amino Acid Cross-Linked Graphene Oxide Membranes for Metal Ions Permeation, Insertion and Antibacterial Properties.
作者信息
Qian Lijuan, Wang Haijing, Yang Jingyi, Chen Xiaolei, Chang Xue, Nan Yu, He Zhuanyan, Hu Peizhuo, Wu Wangsuo, Liu Tonghuan
机构信息
School of Nuclear Science and Technology, Lanzhou University, Lanzhou 730000, China.
Key Laboratory of Special Function Materials and Structure Design, Ministry of Education, Lanzhou 730000, China.
出版信息
Membranes (Basel). 2020 Oct 21;10(10):296. doi: 10.3390/membranes10100296.
Graphene oxide (GO) and its composite membranes have exhibited great potential for application in water purification and desalination. This article reports that a novel graphene oxide membrane (GOM) of ~5 µm thickness was fabricated onto a nylon membrane by vacuum filtration and cross-linked by amino acids (L-alanine, L-phenylalanine, and serine). The GOM cross-linked by amino acids (GOM-A) exhibits excellent stability, high water flux, and high rejection to metal ions. The rejection coefficients to alkali and alkaline earth metal ions through GOM-A were over 94% and 96%, respectively. The rejection coefficients decreased with an increasing H concentration. Metal ions (K, Ca, and Fe) can be inserted into GOM-A layers, which enlarges the interlayer spacing of GOM-A and neutralizes the electronegativity of the membrane, resulting in the decease in the rejection coefficients to metal ions. Meanwhile, GOM-A showed quite high antibacterial efficiency against E. coli. With the excellent performance as described above, GOM-A could be used to purify and desalt water.
氧化石墨烯(GO)及其复合膜在水净化和海水淡化应用中展现出了巨大潜力。本文报道了一种厚度约为5微米的新型氧化石墨烯膜(GOM),它通过真空过滤法制备在尼龙膜上,并经氨基酸(L-丙氨酸、L-苯丙氨酸和丝氨酸)交联。经氨基酸交联的GOM(GOM-A)表现出优异的稳定性、高水通量以及对金属离子的高截留率。通过GOM-A对碱金属和碱土金属离子的截留系数分别超过94%和96%。截留系数随氢离子浓度的增加而降低。金属离子(钾、钙和铁)可插入GOM-A层中,这会扩大GOM-A的层间距并中和膜的负电性,导致对金属离子的截留系数降低。同时,GOM-A对大肠杆菌显示出相当高的抗菌效率。鉴于上述优异性能,GOM-A可用于水的净化和脱盐。